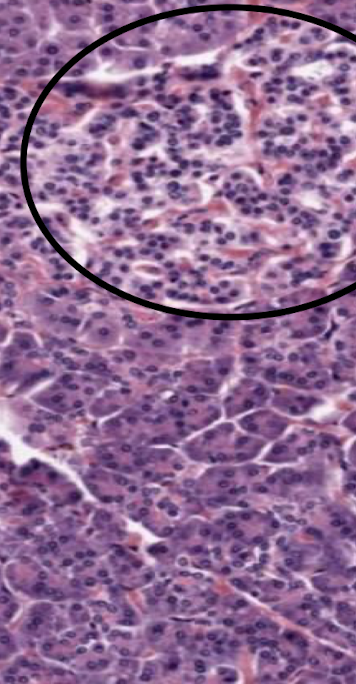
<p>Top portion of the image. Explain the function. </p>
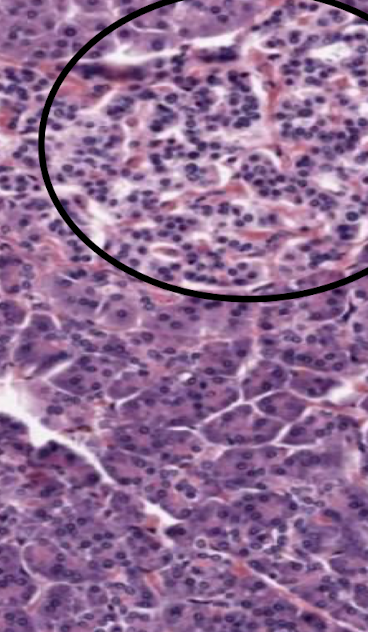
<p>Bottom portion of the image. Classify the tissue.</p>
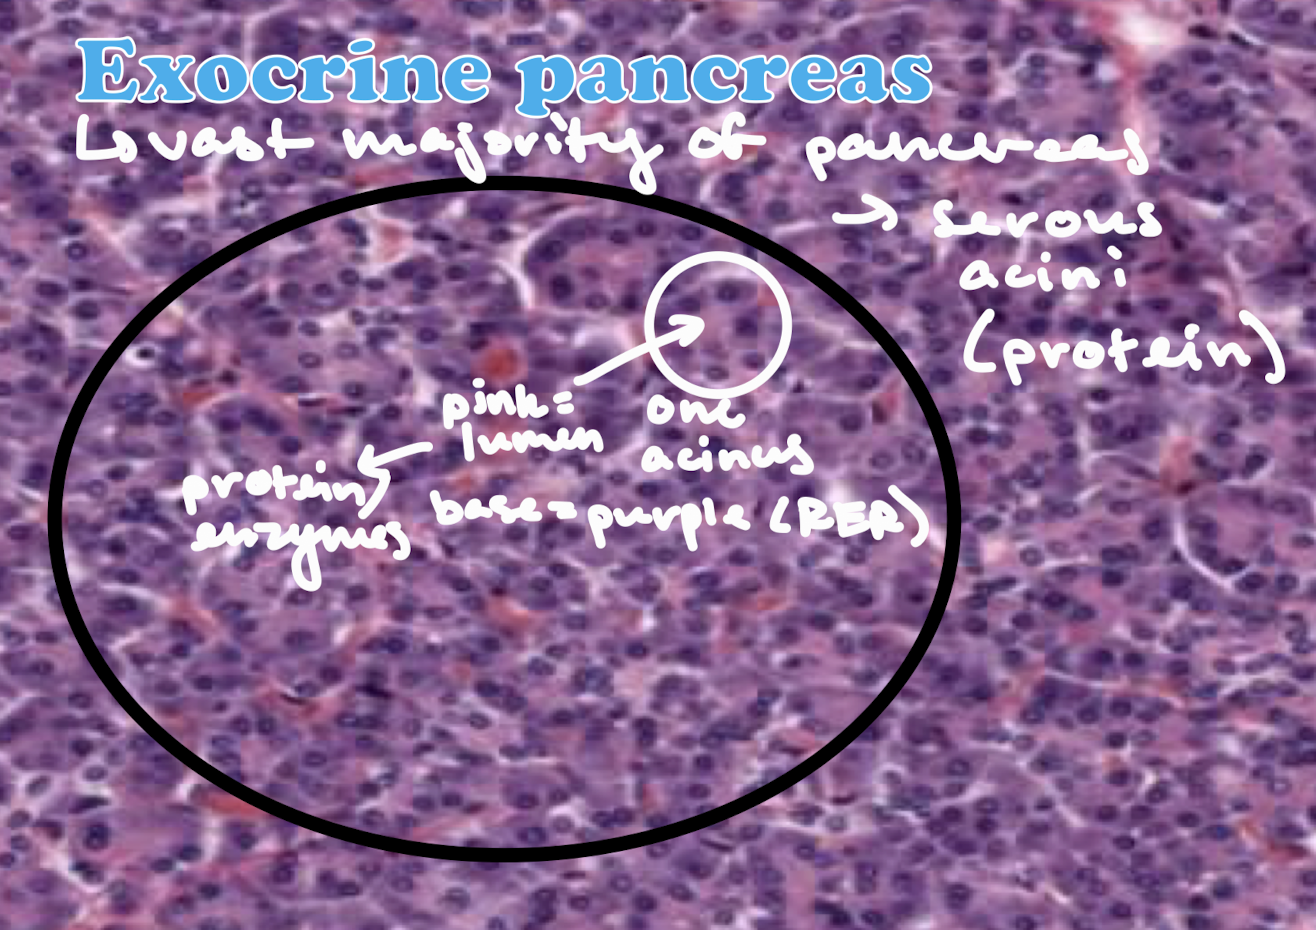
<p>Exocrine pancreas: vast majority of the pancreas. Contains branched serous acini glands that are full of secretory granules that secrete protein. Purple equates to the rough ER and pink to the lumen/protein secretions. </p>

1/23
Looks like no tags are added yet.
Name | Mastery | Learn | Test | Matching | Spaced | Call with Kai |
|---|
No analytics yet
Send a link to your students to track their progress

Label

Top portion of the image. Explain the function.
Endocrine pancreas, a pale island/blob in the pancreas. Made of lots of blood vessels for hormones to go to the blood. Cells produce insulin, glucagon, and somatostatin (islands of Langerhaans)

Bottom portion of the image. Classify the tissue.
Exocrine pancreas: vast majority of the pancreas. Contains branched serous acini glands that are full of secretory granules that secrete protein. Purple equates to the rough ER and pink to the lumen/protein secretions.

Exocrine pancreas: Label


What is the role of these cells? Classify them, too.
The cuboidal intercalated duct cells extend into the acinus. In these areas, the pale stained cells are termed centro-acinar cells. These cells secrete bicarbonate ions which are important for neutralization of acid in the duodenum.


What is the role of these cells?
Serous cells of the branched acinar glands that are packed full of secretory granules containing digestive enzymes.

What are the five or so enzymes produced by pancreatic acinar cells and what are their functions? Include how they are activated if relevant.
Trypsin activated by enterokinase from duodenal brush border so that it is only activated once it reaches the duodenum. Chymotrypsinogen is activated to chymotrypsin by enterokinase. Alpha-amylase (carbs), lipase (lipids), and ribonuclease (nucleotides) also. Generally, these enzymes help digest a meat-y diet.


What cells produce what?
Alpha cells produce glucagon and beta cells produce insulin.


Label. Know the functions/pathways of each.
Hepatic portal vein (afferent) carries blood rich in carbs and proteins from the intestines (accounts for 70-80% of blood flow through liver). Hepatic artery (afferent) carries oxygenated blood from the celiac branch of the aorta ot the liver. The common hepatic duct (efferent) caries bile to the gallbladder. Lymphatics (efferent) carry lymph AWAY from the liver to the thoractic duct.


What does the blue in this picture represent (and function)? What is the border at the very bottom of the image (and function)?
Blue represents CT of type III collagen, or the STROMA. The peritoneum/serosa at the bottom with some CT is Glisson’s capsule.

What is shown in the image? What is the hole in the middle? what is the shape?
Lobule of a pig liver (to see better). Each lobule has a hole in the middle, which is the central vein. The shape is polyganol/hexagonal surrounded by portal triads.

Name the feature
Type III collagen (reticular fibers), silver stain

The opposite of stroma is shown here, which is? What are the white looking lines? What cells are shown in the lobule that are very pink?
Parenchyma (main function of organ). What lines are sinusoids (blood vessels) and the cells are hepatocytes (pink).

The perenchyma is made up of what kind of cells? What are within these cells? How are the cells organized?
Epithelial cells called hepatocytes. They contain glycogen granules and are rich in rough endoplasmic reticulum. They are organized into functional units called lobules.
What makes up the portal triads? Classify the tissue of one, and the source of the other two.
Bile duct (cuboidal epithelium), venule (from hepatic portal vein), and arteriole (from hepatic artery)

How can the portal triad be identified histologically?
Vein is large with thin walls. Artery is smaller but muscular, and duct is cuboidal epithelium.

Describe the structure of each sinusoid. Describe the function and what kind of blood they contain.
Large capillaries that carry blood through the lobule from periphery to the central vein. Contains fenestrated endothelium with incomplete/discontinuous basal lamina. They contain a mixture of arterial blood (hepatic artery) and venous blood (hepatic portal vein).

How does bile get to the bile ducts? Where does it go from there?
Via bile canaliculi (surrounded by plasma membranes of two adjacent hepatocytes) —> hepatic ducts —> bile duct (cuboidal epitheliym) —> gallbladder —> major duodenal papilla


What other cells (aside from hepatocytes) are found in sinusoids? Describe their function.
Kupffer cell macrophages located between sinusoid endothelial cells and within sinusoids. They remove bacteria or debris from the breakdown aged erythrocytes to recycle the heme.


The space that lies between the hepatocytes and sinusoids. Why is it important?
Space of Disse is where hepatocyte microvilli project into the space. Blood in the sinusoids passes through the fenestrations and into the space of Disse where it bathes the hepatocyte microvilli, allowing the exchange of nutrients and metabolites.

How does blood in central vein get to the inferior vena cava?
Sublobar veins —> hepatic veins —> IVC
Smooth muscle thickening in the wall of the duodenum around the major duodenal papilla that controls the flow of bile into the duodenum.
Sphincter of Oddi

What is the function of the gallbladder? What are some identifiers of the gallbladder (4)?
Storage and concentration of bile (adds mucous). Contain rugae of the lamina propria (like the stomach, look like villi but they are not). A perfect example of simple columnar without microvilli and without goblet cells. There is NO muscularis mucosa, and the muscularis externa is randomly organized and thick becasue the function is just to squeeze (the target of CCK).

If the gallbladder is removed, bile is stored where?
Common bile duct